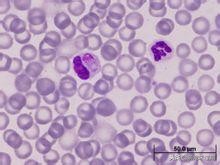
铲屎官对猫做了什么,铲屎官对冬天的猫咪都有哪些误解

犬瘟热是什么
犬瘟热是一种传染性和严重的病毒性疾病,没有已知的治疗方法。这种疾病影响狗和某些野生动物,如浣熊、狼、狐狸和臭鼬。常见的家养宠物雪貂也是这种病毒的携带者。犬瘟热属于莫比利病毒类,是影响人类的麻疹病毒、影响牛的林德伯斯特病毒和引起海豹瘟热的Phocine病毒的*亲近**。他们都是Paramyxoviridae家族的成员。年轻、未接种疫苗的幼犬和未免疫的老狗往往更容易患上这种疾病。犬瘟热不属于人畜共患病。
犬瘟热病毒
犬瘟热的症状和类型
这种病毒通过空气传播,通过与受感染的动物直接或间接(即器皿、床上用品)接触传播,最初攻击狗的扁桃体和淋巴结并在那里复制大约一周。然后攻击呼吸系统、泌尿生殖系统、胃肠道和神经系统。
犬瘟热初期主要表现为高热(39.5℃-41℃)、眼红、鼻、眼水样流出。受感染的狗会变得昏昏欲睡和疲倦,并且通常会变成厌食症。持续咳嗽、呕吐和腹泻也可能发生。在疾病的后期阶段,病毒开始攻击狗身体的其他系统,尤其是神经系统。大脑和脊髓受到影响,狗可能开始发作、癫痫发作、麻痹和歇斯底里发作。

犬瘟热导致的流鼻涕
犬瘟热有时也被称为“硬垫病”,因为某些病毒株可导致动物脚垫的异常扩大或增厚。在免疫系统较弱的狗或动物中,最初感染两到五周后可能导致死亡。

犬瘟热导致的脚掌皮脂增厚
犬瘟的病因
这种疾病可以从不适当的减毒疫苗中获得,虽然这种情况很少发生。呼吸系统或胃肠道系统的细菌感染也可能增加动物对疾病的易感性。未免疫的狗与受感染的动物进行任何形式的接触都具有感染疾病的特别高风险。
犬犬瘟热的诊断
犬瘟热通过生化测试和尿液分析诊断,这也可能显示淋巴细胞数量减少,白细胞在疾病的初始阶段(淋巴细胞减少)在免疫系统中起作用。血清学试验可以鉴定阳性抗体,但是这种试验不能区分接种抗体和暴露于毒性病毒。病毒抗原可在尿沉渣或阴道印迹中检测到。毛发皮肤、鼻粘液和脚垫上皮也可以测试抗体。射线照相只能用来确定感染的动物是否感染了肺炎。计算机断层扫描(CT)和磁共振成像(MRI)扫描可用于检查大脑的任何病变可能已经发展。
犬瘟热的治疗
不幸的是,犬瘟热没有治疗方法。因此,该疾病的治疗主要集中于缓解症状。如果动物已经厌食或腹泻,可以给予静脉支持液。眼睛和鼻子的分泌物必须定期清洗干净。可以开抗生素来控制继发性细菌感染引起的症状,并且可能需要苯巴比妥和溴化钾来控制惊厥和癫痫发作。暂时没有抗病毒药物能有效地治疗这种疾病。
要多陪伴狗狗,多跟它说话,抚摸、鼓励它,主人的鼓励对狗狗来说十分重要!
犬犬瘟热的预防
预防犬瘟的最好方法是接种疫苗和立即隔离受感染的动物。必须特别注意保护新生的幼崽免于暴露,因为它们特别容易感染这种疾病。
真心祈愿天下狗狗都能无病无痛的健康成长~~
关注萌宠未过期,掌握更多的宠物小知识~!